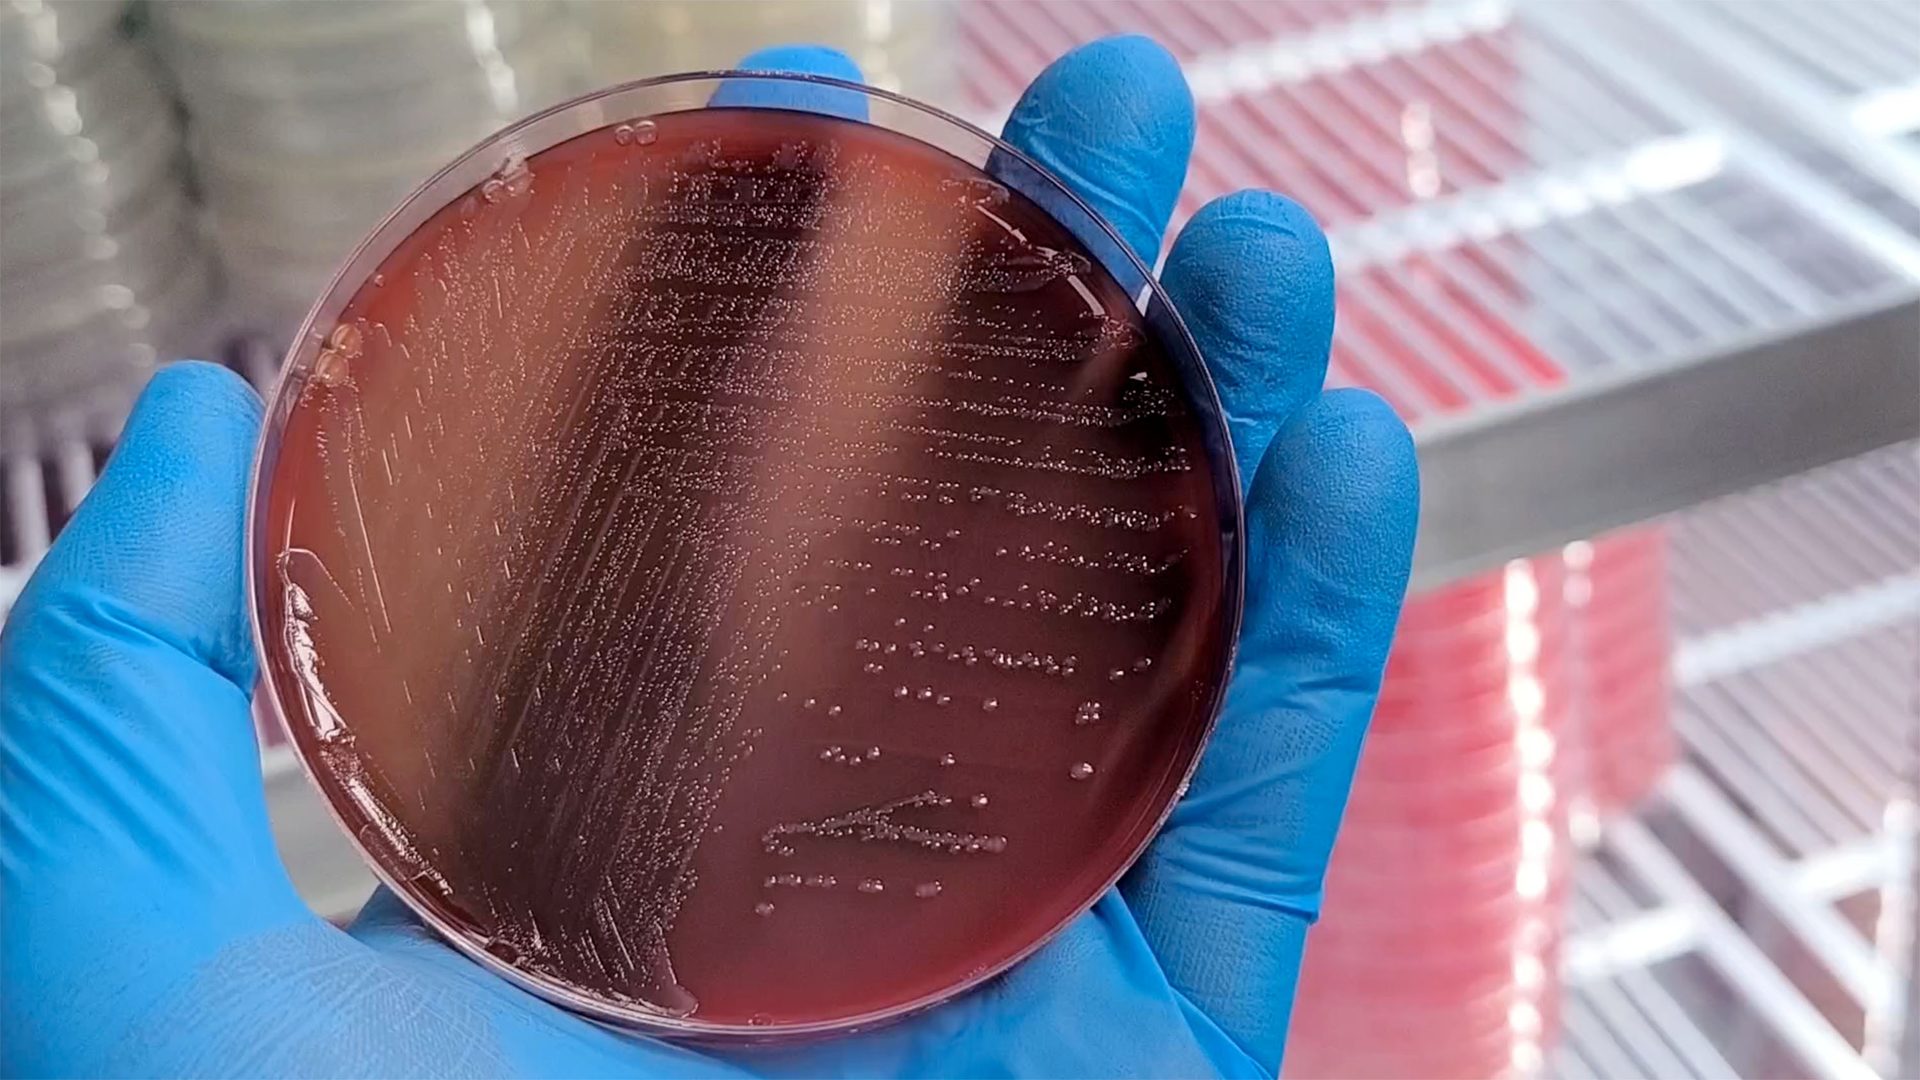
A gloved hand holds a petri dish showing red agar streaked with bacterial colonies.

OCTOBER/NOVEMBER 2025
Vol. 31, No. 6
FEATURES
SCROLL
DOWN

Management: The Synergy Between Food Safety Management and Food Safety Culture in the Governance of Food Safety
By Hal King, Ph.D.

COLUMNS
Food Safety Magazine Advertising Index
This index is provided as a reader service.
The publisher assumes no liability for errors or omissions.
Gary Ades, Ph.D.
G&L Consulting Group
Angela Anandappa, Ph.D.
Alliance for Advanced Sanitation
Jessica Badour
Association of Food and Drug Officials (AFDO)
Srinivasarao Bandla, M.S., PCQI
Land O'Lakes
Jason Bashura, M.P.H., RS
PepsiCo
John N. Butts, Ph.D.
Land O’Frost
Michael Ciepiela
Southern Specialties
Michael M. Cramer (ret.)
Ajinomoto Foods North America
Kurt E. Deibel, Ph.D. (ret.)
Heinz North America
Bob Ferguson
Strategic Consulting Inc.
Timothy A. Freier, Ph.D.
Mérieux NutriSciences
Tatjana Golikova, Ph.D.
National University of Food Technologies
Kathy Gombas
Food Safety Consultant
Randall Huffman, Ph.D.
Maple Leaf Foods.
Lone Jespersen, Ph.D.
Cultivate
Larry Keener, CFS, PA, PCQI
Intl. Product Safety Consultants
Gillian Kelleher
Kelleher Consultants LLC
Hal King, Ph.D.
Active Food Safety
Jeffrey L. Kornacki, Ph.D.
Kornacki Microbiology Solutions Inc.
Bala Kottapalli, Ph.D., CQE
Walmart
Sean Leighton, M.Sc., M.B.A.
Cargill Inc.
Steven Mandernach, J.D.
Association of Food and Drug Officials (AFDO)
Ann Marie McNamara, Ph.D. U.S. Foods
Theodora Morille, M.Sc.
Food Safety Consultant
Stephanie Nguyen, M.Sc.
Conagra Brands
Ian Pearson
Unilever Quality Expertise Group
Robert Powitz, Ph.D., M.P.H., RS
R.W. Powitz & Associates
Thomas M. Sauer
Food Safety Consultant
Nicola L. Stanley, Ph.D.
Global Harmonization Initiative
Richard F. Stier, M.S.
Consulting Food Scientist
Tim Stubbs, CFS
Dairy Management Inc.
Darryl Sullivan
Eurofins Food Integrity and Innovation
John G. Surak, Ph.D.
Surak and Associates
Wendy White, M.Sc.
Georgia Tech Enterprise Innovation Institute